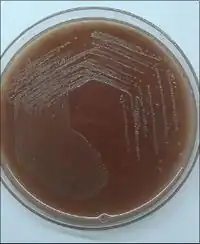

Haemophilus parainfluenzae
| Haemophilus parainfluenzae | |
|---|---|
| Scientific classification | |
| Domain: | Bacteria |
| Kingdom: | Pseudomonadati |
| Phylum: | Pseudomonadota |
| Class: | Gammaproteobacteria |
| Order: | Pasteurellales |
| Family: | Pasteurellaceae |
| Genus: | Haemophilus |
| Species: | H. parainfluenzae
|
| Binomial name | |
| Haemophilus parainfluenzae Rivers 1922 (Approved Lists 1980)[1]
| |
Haemophilus parainfluenzae is a species of Haemophilus.
It is one of the HACEK organisms.[2] H. parainfluenzae is an opportunistic pathogen that has been associated with endocarditis, bronchitis, otitis, conjunctivitis, pneumonia, abscesses and genital tract infections.
Natural genetic transformation
H. parainfluenzae biotypes I and II are capable of natural genetic transformation.[3]
Natural genetic transformation is a bacterial adaptation for DNA transfer. In order for a bacterium to bind, take up and recombine exogenous DNA into its genome it must enter a special physiological state termed natural competence. In H. parainfluenzae, competence is induced during the late stationary phase of growth.[3]
Natural DNA transformation may play a major role in the exchange of genetic information among H. parainfluenzae isolates.
Infection
Acute H. parainfluenzae infections must be treated with antibiotics. Beta-lactam agents such as amoxicillin and ampicillin are antibiotics that are effective against H. parainfluenzae. The Duration of Antibiotic Therapy depends on the severity of the infection. In 40% of infective endocarditis cases caused by H. parainfluenzae, the best treatment is a valve replacement.[4]
References
- ↑ "Species: Haemophilus parainfluenzae". lpsn.dsmz.de. Archived from the original on 2022-12-02. Retrieved 2023-03-19.
- ↑ HACEK Group Infections at eMedicine
- ↑ 3.0 3.1 Gromkova RC, Mottalini TC, Dove MG (1998). "Genetic transformation in Haemophilus parainfluenzae clinical isolates". Curr. Microbiol. 37 (2): 123–6. PMID 9662612.
- ↑ "Canada, P. H. A. of. (2020, December 21). Government of Canada. Canada.ca". Archived from the original on 2023-03-18. Retrieved 2023-03-19.
External links
- "Haemophilus parainfluenzae". NCBI Taxonomy Browser. 729. Archived from the original on 2022-02-14. Retrieved 2023-03-19.
- Type strain of Haemophilus parainfluenzae at BacDive - the Bacterial Diversity Metadatabase Archived 2017-02-18 at the Wayback Machine